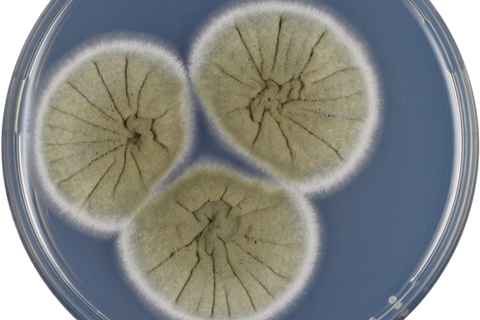

A trio of researchers from the University of São Paulo (USP) and São Paulo State University (UNESP) in Brazil have developed a method to obtain an enzyme from a fungus cultivated in agricultural waste that promotes cellulose pulp bleaching, an important paper production process.
Supported by FAPESP, the study was published in the journal Bio Resources.
Cellulose pulp is typically bleached using chlorine-based oxidizing agents, such as chlorine dioxide. These chemicals are highly toxic and can contaminate wastewater and the atmosphere, releasing gases that are harmful to human health.
In addition to being produced from agricultural waste, the enzyme has the advantage of exhibiting greater thermal stability than many fungal enzymes described in the scientific literature, expanding its potential applications in industry.
“This is a more sustainable alternative for the paper industry that reduces the use of toxic chemicals and whose results show good potential for application. Since Brazil is a global leader in eucalyptus pulp production, developing cleaner bleaching technologies is especially strategic for the country,” says Diandra de Andrades, the first author of the study. She conducted the research as part of her postdoctoral work at the Ribeirão Preto Faculty of Philosophy, Sciences, and Letters (FFCLRP) at USP with a fellowship from FAPESP.
The work is part of the activities of the National Institute of Bioethanol Science and Technology (INCT Bioetanol) and is related to two projects supported by FAPESP (23/01547-5 and 18/07522-6). They are both coordinated by Maria de Lourdes Teixeira de Moraes Polizeli, a professor at the FFCLRP-USP and also an author of the article.
Sourcing xylanase
The obtained enzyme was xylanase, which degrades xylan. Xylan is a hemicellulose found in the cell walls of plants, such as eucalyptus. It can be used in paper and pulp production. Xylanase facilitates the removal of xylan fractions associated with residual lignin in the pulp after industrial wood cooking. This contributes to increased brightness and greater efficiency in subsequent stages of pulp bleaching.
The xylanase was extracted from Aspergillus caespitosus, a soil fungus first described in the United States in 1944 and first isolated at USP in 2001 from samples collected on the Ribeirão Preto campus.
The researchers cultured the fungus on two agricultural residues – sugarcane bagasse and wheat bran – using the solid-state fermentation method. Both substrates were advantageous due to their low cost, ease of fungal growth, and high xylanase production.
Circular bioeconomy
Using sugarcane bagasse and wheat bran aligns the process with the concept of a circular bioeconomy by adding value to abundant Brazilian agroindustrial waste.

“The sugarcane bagasse became more efficient when we pretreated it with sodium hydroxide [caustic soda], which separates the cellulose from the hemicellulose and lignin, facilitating penetration of the fungus into the fibers. Wheat bran, on the other hand, didn’t require pretreatment because it has good availability of carbon, which is the main energy source for the fungus,” explains Polizeli.
However, the researcher emphasizes that local availability is an important factor to consider when choosing a substrate because it can lead to increased costs. In regions with high sugar and ethanol production, such as the interior of the state of São Paulo, sugarcane bagasse would be the most suitable substrate, even considering the need for pretreatment. In wheat-producing regions, such as Rio Grande do Sul state, wheat bran would be the most suitable.
The process
Pulp bleaching cannot be fully carried out using fungal enzymes because the process requires high temperatures that the enzymes cannot withstand. However, over the years, Polizeli’s group has demonstrated that the Aspergillus caespitosus enzyme tolerates temperatures around 60 °C, whereas many fungi cannot withstand much more than 40 °C.
“As the bleaching process progresses in the factory, temperatures gradually decrease. As a result, our enzyme can be used in the final stages of the process, when temperatures are close to 60 °C, acting as a complementary step to conventional chemical bleaching and reducing the need for chlorine dioxide and, consequently, the chemical load of the process,” Polizeli explains.
Currently, the group is exploring ways to immobilize the enzyme on a chemical support so that it can be reused more frequently and withstand higher temperatures.
One promising approach involves using magnetic nanoparticles combined with nanocellulose, which could even be used for enzymes in other industries, such as for producing bioethanol. The results highlight the potential of Brazilian biodiversity as a source of sustainable biotechnologies with industrial applications.
Topics
- Agriculture
- Aspergillus caespitosus
- cellulose pulp bleaching
- Diandra de Andrades
- Economic Equality
- Fungi
- Maria de Lourdes Teixeira de Moraes Polizeli
- Research News
- São Paulo State University
- Strategies for Sustainability
- sugarcane bagasse
- Sustainable Microbiology
- The Americas
- University of São Paulo
- Waste Management
- wheat bran
- xylan
- xylanase







No comments yet